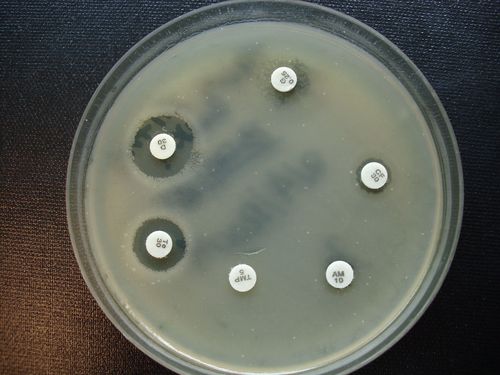

Microbiology Lab Consultant
Price:
Get Latest Price
Brand Name :
Lab Consultation
In Stock
Product Specifications
| Service Type | Consultation |
| Experience | 6 years |
| Reach | Global |
| Methodology | Customised |
| Report Type | Detailed |
| Usage | Microbiology lab setup and design consultation, encompassing regulatory compliance, equipment selection, workflow optimization, and staff training. |
| Compliance | ISO 17025 |
| Features | Expert Advice, Lab Setup, Global Reach, Customer Focus, Six Years Experience |
Company Details
MICROBIO LABORATORY, Established in 2005 at Thane in Maharashtra, is a leading service provider of Analytical Testing Laboratories in India. MICROBIO LABORATORY is one of Trade India's verified and trusted names for listed services. With extensive experience in the field of Analytical Testing Laboratories, MICROBIO LABORATORY has made a reputed name for itself in the market with satisfactory Antimicrobial Effectiveness Testing, Antimicrobial Testing Services, Environmental Soil Testing Services, etc.
Focusing on a customer-centric approach, MICROBIO LABORATORY has a pan-India presence and caters to a huge consumer base throughout the country. Get Analytical Testing Laboratories from MICROBIO LABORATORY at Trade India quality-assured services.
Focusing on a customer-centric approach, MICROBIO LABORATORY has a pan-India presence and caters to a huge consumer base throughout the country. Get Analytical Testing Laboratories from MICROBIO LABORATORY at Trade India quality-assured services.
Business Type
Service Provider
Employee Count
4
Establishment
2005
GST NO
27ABEPR7977G1Z0
More Product From This seller
Seller Details

GST - 27ABEPR7977G1Z0
Thane, Maharashtra
Director
Mrs. Sumitra S. Rao
Address
No-39, Asiatic Arcade, Vartak Nager, Pokhran Road, No. 1, Thane (w), Thane, Maharashtra, 400606, India
Analytical Testing Laboratories in Thane
Report incorrect details